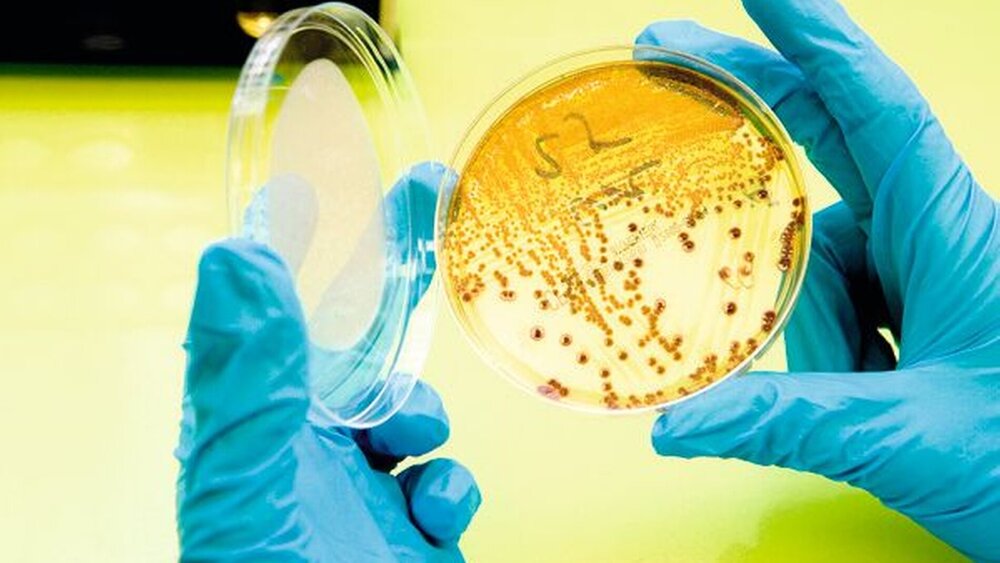

Der Faktor Mensch
„Krankenhausinfektionen kann man nur selten vermeiden, sie treten quasi schicksalhaft auf, und im Übrigen bringen die Patienten die Erreger selbst mit.“ Das sind für Dr. med. Klaus-Dieter Zastrow, Vivantes-Kliniken Berlin, die drei „kapitalen Fehlaussagen“, wenn es um nosokomiale Infektionen geht. Der Sprecher der Deutschen Gesellschaft für Krankenhaushygiene räumt zwar ein, natürlich stamme ein Großteil der Erreger aus der Normalflora der Patienten. Das gelte etwa für Operationen im Gastrointestinaltrakt. Bei aseptischen Operationen allerdings, also zum Beispiel einem Gelenkersatz, beruhten Infektionen auf mangelnder Hygiene. Umso mehr, wenn keine Haut-, sondern beispielsweise Darmkeime nachgewiesen würden.
Wieso kommt der MRSA aus der Nase ins Gelenk?
Besonders gefährdet, eine nosokomiale Infektion zu entwickeln, sind drei Patientengruppen: sehr junge, sehr alte und sehr kranke. „Aber auch bei älteren oder abwehrgeschwächten Patienten ist nicht automatisch ein E. coli in der Hüfte“, sagte Zastrow auf der MCC-Konferenz Krankenhaushygiene in Köln. Selbst, wenn der Patient bereits vor seinem stationären Aufenthalt mit einem Methicillinresistenten Staphylococcus aureus (MRSA) besiedelt sei, müsse man sich fragen, wie der Keim aus der Nase ins Gelenk komme.
Wer eine Antwort auf diese oder ähnliche Fragen sucht, für den liefern die Zahlen des nationalen Krankenhaus-Infektions-Surveillance-Systems (KISS) interessante Anhaltspunkte: Auf 19 Prozent der teilnehmenden Intensivstationen gab es demnach 2008 keinen schriftlich fixierten Standard für die Anlage eines zentralen Venenkatheters (ZVK). Zugleich screenen lediglich 23 Prozent der Kliniken routinemäßig die Mitarbeiter, die Kontakt zu Patienten mit multiresistenten Erregern hatten. Letzteres geht aus dem „Krankenhaus-Barometer“ des Deutschen Krankenhausinstituts (DKI) hervor. Wenn dann beispielsweise bei einer ZVK-Anlage kein Mundschutz verwendet oder nichts über die Nase gezogen wird, ist das Risiko offensichtlich. Ein Erkenntnisproblem gibt es diesbezüglich nicht. Aus einer Empfehlung des Robert-Koch-Instituts (RKI) geht eindeutig hervor: Die Häufigkeit einer katheterassoziierten Infektion kann signifikant gesenkt werden, wenn die Person, die ihn legt, sich steril kleidet, mit einem langärmligen Kittel, Mund-Nasen-Schutz, Haube und sterilen Handschuhen.
Die Empfehlungen der Kommission für Krankenhaushygiene und Infektionsprävention (KRINKO) des RKI liefern ausführliche Handlungsanweisungen. Sie seien zudem evidenzbasiert, und die Kommission leiste eine hervorragende Arbeit, lobt Zastrow. Rechtlich bindend sind sie aber bisher nicht. Es sieht aber so aus, als könnte sich das bald ändern. Die schwarz-gelbe Regierungskoalition plant zurzeit ein Hygienegesetz. Damit könnten die Länder verpflichtet werden, Hygieneverordnungen zu erlassen. Die gerade in Bayern in Kraft getretene Verordnung beispielsweise verzichtet in vielen Punkten auf Details und verweist stattdessen auf die KRINKO-Empfehlungen, lässt allerdings auch ein abweichendes Vorgehen zu, wenn es geeignet ist (siehe Kasten).
Gesetzgeber wird noch in diesem Jahr aktiv
Dass der Gesetzgeber nun aktiv wird, liegt auch an dem anhaltenden öffentlichen Druck. Über Krankenhausinfektionen wird seit einigen Monaten in den Medien regelmäßig berichtet. Anlass sind immer wieder „Hygiene-Skandale“. Doch wie groß ist das Problem tatsächlich?
Die umfassendste Sammlung von Informationen dazu sind sicherlich die KISS-Daten. Die Teilnahme der Krankenhäuser an diesem Meldesystem ist freiwillig. Aus den KISS-Zahlen und Daten des Statistischen Bundesamtes erstellt das an der Berliner Charité angesiedelte Nationale Referenzzentrum für Surveillance von nosokomialen Infektionen (www.nrz-hygiene.de) Hochrechnungen. Demnach gab es 2008 etwa 500 000 nosokomiale Infektionen. 7 500 bis 15 000 Menschen sterben an Infektionen, die sie im Krankenhaus erworben haben. Die KISS-Zahlen werden allerdings angezweifelt. Manche halten sie für zu niedrig, schließlich beteiligten sich gerade die Kliniken, für die Hygiene ohnehin im Blickfeld stehe. Dr. Karl Blum vom DKI beklagt ebenfalls eine unzureichende Datenlage, was die Prävalenz und die Folgekosten nosokomialer Infektionen angeht. Aus seiner Sicht zeigen jedoch die Ergebnisse des Krankenhaus-Barometers, dass die Strukturqualität der Krankenhäuser auf einem guten Niveau ist. Hygienekommissionen und -pläne gebe es in etwa 99 Prozent der befragten Kliniken. Nachholbedarf sieht er vor allem im Bereich Prozessqualität.
Wie aber misst man gute Hygiene? Ist die Zahl nosokomialer Infekte allein aussagekräftig? Oder sollte man den Verbrauch an Desinfektionsmitteln bestimmen? Viele Experten sind der Meinung, dass es dazu noch zu wenige Erkenntnisse gibt, und stehen deshalb einem Hygienesiegel für Kliniken skeptisch gegenüber.
So auch Prof. Joachim Szecsenyi vom AQUA – Institut für angewandte Qualitätsförderung und Forschung im Gesundheitswesen. Zunächst müsse es darum gehen, geeignete Indikatoren zu entwickeln. Derzeit bereite eine Arbeitsgruppe des Gemeinsamen Bundesausschusses (G-BA) einen entsprechenden Auftrag für das AQUA-Institut vor. Ein Abschlussbericht für ein sektorenübergreifendes Qualitätsinstrument soll voraussichtlich im Sommer 2012 vorliegen.
Führungskräfte sind starke Vorbilder
Vorgaben für gute Qualität sind eine Sache, deren Umsetzung eine andere. Eine zentrale Rolle beim Thema Hygiene spielt der Faktor Mensch – nicht nur, weil Patienten Erreger mitbringen oder Mitarbeiter Keime übertragen. „Wir haben hier ein Top-down-Problem“, erklärt Zastrow. Führungskräfte müssten das korrekte Verhalten vorleben und dürften Fehlverhalten nicht ignorieren. Auch Ausreden will Zastrow nicht gelten lassen. „Personalmangel ist keine Entschuldigung für mangelnde oder falsche Hygiene“, sagt er. Das Anlegen eines Mundschutzes dauere fünf Sekunden, eine Händedesinfektion 30 Sekunden. Zastrow ist davon überzeugt, dass nur Fachpersonal das notwendige Bewusstsein vermitteln kann. Deshalb brauche man mehr Fachärzte für Hygiene und weitere Hygienefachkräfte.
Nosokomiale Infektionen kann man nicht losgelöst vom Thema Antibiotikatherapie betrachten. Denn Probleme machen insbesondere die resistenten Keime. 132 000 MRSA-Fälle hat es nach den Hochrechnungen des NRZ 2008 in deutschen Krankenhäusern gegeben. „Die Zahl liegt auf einem relativ hohen Niveau, ist aber konstant“, wie Prof. Martin Mielke vom RKI erläutert. Deutlich zugenommen haben unterdessen die Resistenzen im gramnegativen Bereich – unter anderem die Extended-Spectrum-Betalaktamase( ESBL)-bildenden Stämme von Klebsiella, Escherichia coli und andere Enterobacteriaceae. Sie reagieren nicht mehr auf Cephalosporine der dritten Generation. Die Ursachen für die Resistenzentwicklung liegen für Mielke auf der Hand: Der Einsatz von Antibiotika sei oft nicht gezielt – bezüglich seiner Art und Dauer. In den Niederlanden, die immer als Vorbild in der Infektionsprävention gelten, würden im ambulanten Bereich kaum Oralcephalosporine und Chinolone eingesetzt. In Deutschland beobachtet er eine Überschätzung der Resistenzlage, daher werde oft zu breit therapiert.
Tatsächlich werden schon bei unkomplizierten Harnwegsinfekten im ambulanten Setting häufig Fluorchinolone verordnet. Die Deutsche Gesellschaft für Allgemeinmedizin und Familienmedizin empfiehlt jedoch in ihrer Leitlinie „Brennen beim Wasserlassen“ für diese Indikation Trimethoprim (TMP) als Mittel der ersten Wahl. Eine dreitägige Behandlung sei ausreichend. Die Kombination von TMP mit Sulfamethoxazol biete im Vergleich zur Monosubstanz keine Vorteile (www.degam.de). Vielfach gebe es jedoch die Annahme, dass eine solche Therapie nicht ausreiche. „Das ist ein schwieriger Überzeugungsprozess“, sagt Szecsenyi.
Mielke zufolge beeinflusst der Einsatz von Chinolonen auch die MRSA-Ausbreitung. Zur Therapie solcher Keime sind diese Antibiotika freilich ungeeignet. Mehr als 97 Prozent der im Krankenhaus erworbenen MRSA reagieren nicht auf Ciprofloxacin. Je häufiger aber die breit wirkenden Chinolone eingesetzt würden, desto größer sei der Selektionsvorteil für MRSA gegenüber anderen Erregern.
Der Artikel wurde von Dr. med. Birgit Hibbeler verfasst und ist im Original im Deutschen Ärzteblatt (5/2011) erschienen.